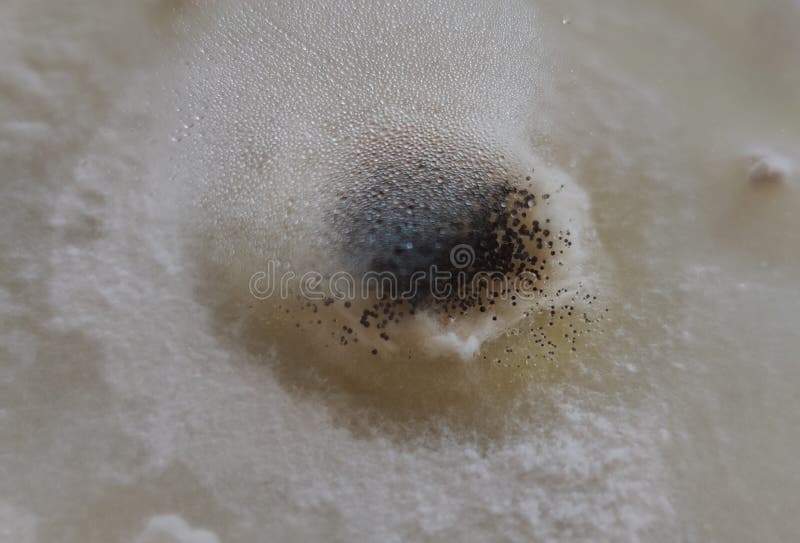
Aspergillus niger colony on a textile sample stock photos
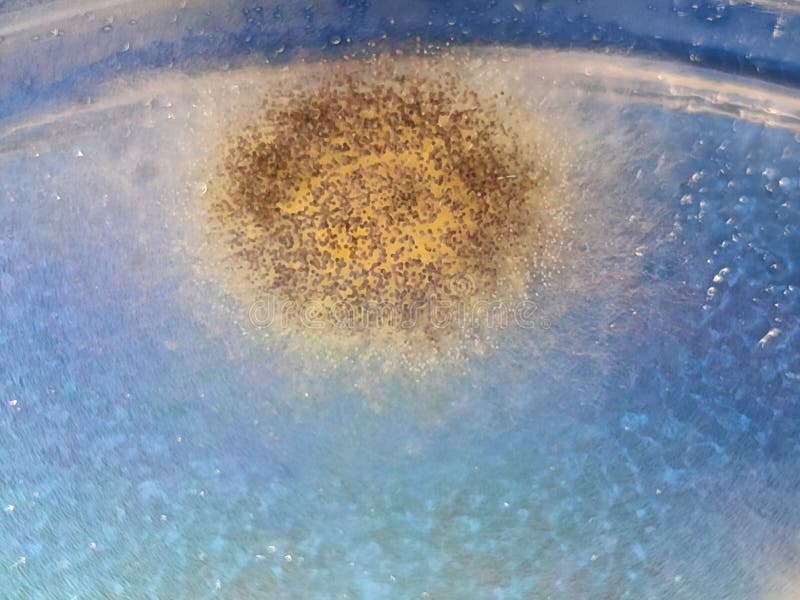
Aspergillus niger colony on saboraud dextrose agar medium royalty free stock photography

Royalty-Free Stock Photo
Aspergillus niger conidia and sporea under the microscope. Microscopy of the conidia of the Aspergilluis niger mold, fungal biology microbiology nature photography
- ?
$62.50USD
$150.00USD
$250.00USD
Size MAX
6474x8589px •
21.6" x 28.6" • @300dpi •
16.2MB • jpg
Author credit line